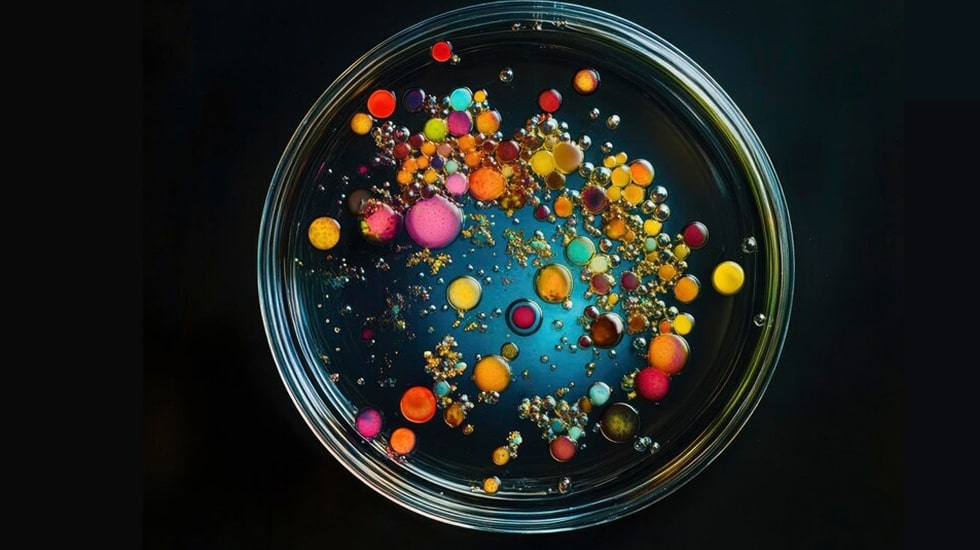

Quick Access to Article Sections
- What Is Eyelash Glue and How It Works
- Common Eyelash Glue Side Effects You Should Know
- Allergic Reactions and Eye Irritation
- Eyelid Swelling and Contact Dermatitis
- Long-Term Side Effects and Sensitivity Build-Up
- Respiratory or Fume-Related Reactions
- Toxic Ingredients to Avoid in Lash Adhesives
- How to Prevent Eyelash Glue Allergies and Reactions
- Safe & Sensitive-Skin Approved Lash Glues | WINLASH Dubai
- FAQs About Eyelash Glue Safety
Whether you’re a lash artist or a client who loves extensions, understanding eyelash glue side effects is essential. The adhesive that holds those beautiful extensions can sometimes cause redness, irritation, or allergic reactions, especially if low-quality glue is used or proper precautions aren’t taken. In Dubai’s hot and humid climate, the risk of irritation can be intensified – high temperatures and moisture can make glue fumes stronger and curing times unpredictable. Today we’ll deep-dive into the common side effects of lash extension glues, why they occur, and how to prevent them. We’ll also highlight safe alternatives (like latex-free, low-fume adhesives) and professional tips to keep your eyes comfortable. (Psst… if you’re looking for safe products, Winlash specializes in low-fume, hypoallergenic lash adhesives tailored for the UAE climate.)
What Is Eyelash Glue and How It Works

Eyelash extension glue is a specialized adhesive designed to bond individual extensions to your natural lashes. Unlike temporary strip lash glue (often latex-based), extension glues rely on cyanoacrylate – the same family of fast-acting adhesives as surgical glue or “super glue.” When applied, cyanoacrylate adhesives polymerize (harden) in seconds upon contact with moisture in the air. This creates a strong, semi-permanent bond that can keep extensions in place for weeks.
Key components found in professional lash adhesives include cyanoacrylate (the main active ingredient), stabilizers, and sometimes pigments like carbon black (for black-colored glue). Quality lash glues are formulated to dry quickly and hold strongly under various conditions (oil, water, heat). For example, many professional eyelash adhesives boast retention times of several weeks and specific optimal temperature/humidity ranges for use. The glue’s quick setting nature is what allows lash techs to attach extensions one by one without them sliding off.
It’s important to note that because these glues are so potent, they must be used carefully. They should never touch the skin or eyes directly – only the lash fibers. And while effective, the chemicals in lash glue can cause issues if the glue is poor quality or if a client is sensitive. The next sections explore the side effects of eyelash extension glue and how to address them.
Common Eyelash Glue Side Effects You Should Know
Even with proper application, some clients experience side effects from lash adhesives. Here are the most common issues to watch for:
Allergic Reactions and Eye Irritation
Allergic reaction to eyelash glue is one of the most frequent (and uncomfortable) side effects. It can manifest as intense redness, itching, swelling, or rash on the eyelids and eye area. Some people even develop hives or blisters around the eyes in severe cases. An allergic reaction is caused by your immune system overreacting to a glue ingredient – often formaldehyde or cyanoacrylate.
By contrast, eye irritation (without an immune allergy) can happen to anyone if glue fumes get in the eye. Have you ever felt your eyes burn or water during a lash appointment? That’s usually due to strong adhesive vapors. The vapors from certain glues can cause burning, itching, and bloodshot eyes even if you’re not truly allergic. This is why lash techs ask you to keep your eyes closed throughout the application – to minimize exposure to fumes.
How common are these reactions? Studies show a significant number of extension users experience mild symptoms – one survey found up to 38% of people report eyelid itching after getting lash extensions. Itchiness and redness that appear within a day or two post-appointment are telltale signs of a glue allergy or sensitivity. If you notice these, you should have the extensions removed and treat the reaction (more on treatment below).
Why do allergic reactions happen? The main culprits are glue ingredients: particularly formaldehyde (a preservative/byproduct) and the cyanoacrylate itself. Even glues labeled “formaldehyde-free” may release tiny traces of formaldehyde as they cure, which can trigger sensitive individuals. Also, if you have a history of allergies (for example, to latex or certain cosmetics), you’re at higher risk of reacting to lash adhesive. However, anyone can develop an allergy over time – you might be fine for months and then suddenly become allergic due to repeated exposure.
Eyelid Swelling and Contact Dermatitis

If your eyelids become puffy, red, and itchy after lash extensions, you might be experiencing contact dermatitis from the glue. Eyelid swelling often accompanies allergic reactions; the delicate eyelid skin inflames easily when irritated. In severe cases, the entire eye area can puff up, and eyes may be difficult to open.
Contact dermatitis is a skin inflammation caused by direct contact with an allergen or irritant – in this case, something in the lash glue. You might see red, scaly patches or a rash on the upper or lower lids a day or two after your appointment. The skin may flake or peel (like eczema) as it heals. This type of reaction can result from formaldehyde, latex, or other chemicals in the adhesive touching the skin. It can also occur if the under-eye pad or tape (used during application) had an adhesive you’re sensitive to.
Important: Swollen, irritated eyelids should not be ignored. Besides discomfort, severe swelling could indicate the onset of anaphylaxis (a serious allergy). If you ever have trouble breathing or swallowing along with eyelid swelling, seek medical help immediately. Fortunately, most glue-related swelling subsides once the irritant is removed and treated.
Long-Term Side Effects and Sensitivity Build-Up
What about long-term effects of repeated eyelash extension use? One concern is that you can develop a sensitivity or allergy over time even if you’ve never had issues before. Each exposure to the glue gives your immune system another chance to recognize it as a threat. For some people, the sensitization builds up slowly: after many extension fills, they suddenly experience itching or swelling that they never had in the past. Essentially, an allergy can develop out of the blue after long-term use of lash adhesives.
Another long-term consideration is the effect on your natural lashes and eyes. While the glue itself doesn’t directly make lashes fall out, chronic inflammation from allergic reactions could potentially weaken your lash follicles over time. Additionally, if a person continually ignores mild reactions, they could risk more severe reactions later with continued exposure.
For lash technicians who work with adhesives daily, long-term exposure to fumes can sometimes lead to occupational allergies (e.g. flu-like symptoms or contact dermatitis on fingers). This is why many lash pros wear masks and ensure ventilation when working with strong glues.
In general, if you find yourself becoming more sensitive to lash glue as time goes on, consider switching to a sensitive formula adhesive or taking a break from extensions to allow your eyes to recover. It’s not worth risking a serious allergy. (We’ll discuss hypoallergenic glue options in the Prevention section.)
Respiratory or Fume-Related Reactions
The strong smell of lash glue isn’t just unpleasant – in some cases, fumes can irritate your respiratory system. If you’re in a small room with poor air flow, the evaporating cyanoacrylate can cause throat irritation, coughing, or a runny nose. Some clients even report getting a headache or dizziness from inhaling lash glue fumes for an extended period.
For extremely sensitive individuals (or those with asthma), glue fumes may trigger breathing difficulties. This is rare in a normal lash appointment (since your eyes are closed and direct inhalation is limited), but lash artists who do multiple clients a day need to be cautious. Overexposure to vapors like formaldehyde can lead to symptoms such as headaches, nausea, or chest tightness.
Another fume-related issue is the burning sensation in the eyes some clients feel during or right after application. If your eyes water or sting when the extensions are being applied, it’s often because adhesive vapor is contacting your eye. This can happen if you accidentally open your eyes too soon, or if the technician is using a very strong glue without sufficient drying/ventilation. “Why does lash glue burn my eyes?” Simply put, it’s the chemical fumes interacting with the moisture on your eye’s surface, causing irritation. Low-quality glues with excessive fumes, or even good glues used in low humidity (which slows drying and lets fumes linger), are usually to blame.
Tip: If you know you’re prone to tearing or stinging, ask your lash tech to use a low-fume lash glue and to keep a small fan or air circulator on during your appointment. Proper ventilation will carry away the fumes so they don’t hover around your eyes. Salons in Dubai should be mindful of this, as constant air-conditioning plus high outdoor humidity can create fluctuating conditions where fumes either get trapped or curing is erratic.
Toxic Ingredients to Avoid in Lash Adhesives
Not all lash glues are created equal. Some contain harsh chemicals that dramatically increase the risk of side effects. As a consumer (or lash artist), you should check for these toxic ingredients and opt for adhesives that avoid them:
Formaldehyde and Its Derivatives
Formaldehyde is public enemy #1 when it comes to eyelash glue safety. This colorless gas is a known irritant and allergen – it’s even classified as a carcinogen (cancer-causing) at high exposures. In the context of lash glue, formaldehyde can be present in two ways: added intentionally as a preservative in some cheap adhesives, or released in trace amounts as a byproduct of cyanoacrylate curing. Both are bad news for your eyes.
Why avoid formaldehyde? It can cause instant burning, redness, and swollen eyelids upon exposure. Over time, it might even contribute to natural lash shedding or recurrent eye infections. The California Board of Barbering and Cosmetology explicitly recommends never using any adhesive that contains formaldehyde because of how toxic it is around the eyes.
Most professional-grade glues today advertise as “formaldehyde-free.” Still, due to the nature of cyanoacrylate, no lash glue is 100% free of formaldehyde traces – but premium brands keep the amount so microscopic that it’s undetectable and unlikely to cause harm. The key is to avoid cheap glues (the kind found in unregulated markets or some DIY kits) which might have formaldehyde or release a strong pungent odor (a giveaway sign). Always choose adhesives from reputable manufacturers that prioritize safety.
Latex and Carbon Black
If you have latex allergies, pay close attention: some eyelash adhesives (particularly older formulas and many strip lash glues) contain latex, a rubbery ingredient that helps glue stay flexible. Latex is a common allergen—it can cause severe itching, swelling, and even blisters on the skin it touches. While most eyelash extension glues are latex-free (they use cyanoacrylate instead for the bonding power), it’s worth double-checking. Even a small amount of latex in the glue or under-eye pads can trigger a major reaction for allergic individuals. Always look for “latex-free eyelash glue” on the label (many sensitive or medical-grade adhesives will highlight this).
Carbon black is another ingredient to consider. This is a black pigment added to many lash glues to give them a deep black color (so the adhesive blends with your eyeliner and lashes). Carbon black itself is essentially a fine charcoal powder. It’s not toxic per se, but it can be an allergen for some people or cause irritation if it migrates into the eye. If someone has very sensitive skin or a history of reactions to hair dyes (which often contain similar carbon-based pigments), a black glue could pose an issue. The solution here is to use a clear eyelash glue – these formulas omit the pigment (they look white or translucent when applied, and dry clear). Clear glues are generally slightly gentler simply because they have one less ingredient (pigment) that could cause sensitivity. So if a client’s eyes always get red with black glue, switching to clear might help.
Fragrances and Other Additives
Some lower-quality adhesives add extra fragrances or additives to their formulas – for example, to mask a chemical smell or to market a “soothing” scent. Fragrance in any skincare or eye product can be a recipe for allergy. The delicate eye area doesn’t need perfume! If you see things like “Parfum” or unnecessary botanical extracts in a lash glue’s ingredient list, think twice. These additives can cause contact dermatitis or watering eyes.
Other additives to be cautious of include certain stabilizers or enhancers that aren’t common in reputable brands. For instance, some glues might have formamide or other chemicals that help with drying time but are not eye-friendly. Cyanoacrylate itself is the core ingredient required for adhesion; anything beyond the basic formula (cyanoacrylate + stabilizer like PMMA + perhaps carbon black) should be scrutinized. This is why using medical-grade or professional eyelash adhesives is important – they tend to use purer formulas without random cheap fillers.
| Ingredient | Risk | Who Should Avoid | Safe Option |
|---|---|---|---|
| Formaldehyde | Burning, redness, swelling, long-term irritation | All users, especially sensitive eyes | Formaldehyde-free, medical-grade adhesive |
| Latex | Allergic rash, itching, blisters | People with latex allergy or eczema | Latex-free lash glue |
| Carbon Black | Irritation, pigment allergy | Very sensitive skin or dye-allergic users | Clear or transparent adhesive |
| Fragrance | Tearing, dermatitis, burning | Sensitive or allergy-prone clients | Fragrance-free formulas |
| Harsh Additives | Unknown irritation, poor quality | All users | Professional, hypoallergenic glues |
In summary, stick to lash glues that emphasize being formaldehyde-free, latex-free, and fragrance-free. Check the ingredient list if available, and when in doubt, choose products from brands known in the lash industry (they have a reputation to uphold and can’t afford to use nasty ingredients). In the next section, we’ll discuss how to proactively avoid side effects – including selecting the right glue.
How to Prevent Eyelash Glue Allergies and Reactions

Preventing side effects starts before you ever get your lashes done. A few smart steps can dramatically reduce your risk of experiencing any nasty surprises:
Always Do a Patch Test Before Application
If you’re trying a new glue or it’s your first time getting extensions, insist on a patch test. A patch test involves placing a small amount of the lash glue (often with a couple of extensions) on your skin or lashes at least 24–48 hours prior to the full appointment. This way, you can see if any redness or itching develops in a controlled, small area. No reaction = likely good to go. But if you do react, you’ve saved yourself a full-blown eye disaster by finding out early.
Many professionals will apply a few lash extensions at the outer corner of your eye as a test, or even stick a drop of glue on the inside of your forearm or behind your ear. Performing a patch test is vital – it’s the easiest way to know if you’re allergic to a product. In fact, it’s recommended for everyone, but especially if you have sensitive skin or a history of allergies. (Some estimates say about 5% of people will experience an allergic reaction to lash extension glue – patch testing helps catch those individuals in advance.) If your salon doesn’t offer patch tests, ask for one or consider finding a salon that takes this precaution seriously.
Choose Hypoallergenic & Professional-Grade Adhesives
One of the best prevention strategies is simply using a better glue. Not all adhesives cause the same level of irritation. Look for hypoallergenic eyelash glue options – these are formulas specifically made for sensitive eyes. They are typically formaldehyde-free, latex-free, and often labeled “low-fume” or “sensitive.” For example, professional brands might offer a “sensitive adhesive” that has a slightly slower drying time but produces far less vapor, thereby minimizing eye irritation.
When we say professional-grade, we mean glues that are used by certified lash technicians and come from reputable manufacturers (not a random cheap bottle from an unknown source). Reputable lash brands avoid the harshest chemicals – for instance, they don’t use the most irritating type of cyanoacrylate (methyl cyanoacrylate). Instead, they use ethyl or butyl cyanoacrylate which have a good balance of strong bonding but lower fumes. Some advanced adhesives even use octyl cyanoacrylate, which is used in medical glues for its gentleness (though these can be less durable).
If you have extremely sensitive eyes, you might also opt for clear adhesive (no carbon black pigment) as noted earlier, or glues marketed as “for sensitive eyes”. These usually have “low-irritation lash glue” or similar on the label. Also, prefer adhesives that explicitly say “formaldehyde-free” and “latex-free” – most quality products do.
In Dubai and the UAE, because of the climate, also look for glues that can handle humidity without excessive fumes. A low-fume lash glue designed for use in humid conditions (like many offered by Winlash) will help prevent the “burning eyes” issue. Essentially, by choosing a safe eyelash extension glue from the get-go, you eliminate many risk factors for side effects. It’s an upfront investment in comfort and eye health.
(Internal Tip: Winlash Dubai offers a curated selection of sensitive, hypoallergenic eyelash glues. We’ll highlight a couple of top options later in this article, so you know what to look for.)
Maintain Proper Salon Ventilation and Humidity
The environment where your lash application takes place plays a big role in whether you’ll feel irritation. Ventilation is key. Lash adhesive fumes are heaviest during the few seconds of drying/curing. If those fumes build up around your face, you’re more likely to get teary or irritated. A well-ventilated space – whether through an open door, a fan, or an air purifier – disperses the vapors. Lash studios should have extraction fans or at least circulate air to pull fumes away from you and the technician.
Additionally, humidity and temperature need to be in the right range. Every professional glue has a recommended temperature and humidity range for optimal curing (for example, 20–24°C and 50–60% humidity). Extremes can cause issues:
- In excessively humid conditions (like Dubai’s summers or a room with no dehumidifier), glue can cure too fast, potentially causing a burst of heat and fumes (and sometimes a whitening effect called “blooming”). It can also make lash bonds brittle. Using a dehumidifier or an adhesive formulated for high humidity can help.
- In very low humidity (dry air-conditioned rooms), glue cures slowly and can emit fumes for longer. This is often when clients feel that prolonged eye sting. Solutions: use a humidifier to reach the ideal moisture level, or use a glue optimized for low humidity.
For Dubai specifically, many salons battle between the outdoor humidity and indoor AC. Lash artists should monitor their room conditions and adjust. As a client, it doesn’t hurt to ask your technician if they’ve accounted for the climate (“Do you use a glue that’s good for high humidity?” or “Is the room humidity controlled?”). A pro will know exactly what you mean and have measures in place – like using a hygrometer to measure humidity and adjusting the glue or environment accordingly.
Lastly, a nifty tool is a nano-mister – a device that sprays a fine mist of water to help cure adhesive immediately after lash application. Lash techs sometimes use it to instantly “seal” the glue and eliminate lingering fumes, which can significantly cut down on post-application irritation. Ensuring your salon does things like this indicates they take glue fumes and client comfort seriously.
What to Do If You Experience Side Effects

Sometimes, despite all precautions, you might still end up with an itchy or swollen surprise. Don’t panic. Here’s how to handle common eyelash glue side effects safely:
- If you feel burning or irritation during application: Speak up right away. It might be as simple as closing your eyes more fully, or you might need a fan to blow away fumes. A good lash tech will pause and address it (for example, letting your eyes rest or switching to a gentler glue). Never just “push through” intense burning – that could lead to a chemical burn on your eye. It’s okay to stop the procedure if needed.
- For mild redness or irritation after (no swelling): Try using a cold compress on your closed eyes as soon as you get home. Cold compresses can soothe redness and that dry, irritated feeling. Over-the-counter lubricating eye drops or artificial tears can also help rinse out any irritants and relieve dryness.
- For allergic reactions (swelling, itching, rash): The first step is to remove the lash extensions and glue. It’s best if you can return to your salon or a professional to have them removed with proper solution – don’t try to rip or pull them off, as that can further irritate your skin and eyes. Removing the source of the allergen is crucial. After removal, you can use antihistamines to calm the allergic response: oral antihistamine pills (like cetirizine or Benadryl) and/or anti-allergy eyedrops can reduce swelling and itching. A 1% hydrocortisone cream can be gently applied to the eyelids if the irritation is on the skin (careful to avoid getting it in your eyes)– this can ease rash and inflammation. If your lids are very swollen, an ice pack (wrapped in a cloth) can bring relief too.
- Watch and wait (but not too long): Mild symptoms should start improving within about 24 hours after removal and treatment. If you still have significant redness, swelling, or pain after 48 hours, see a doctor. You might need prescription-strength eye drops or even a short course of steroids to calm a severe reaction. Also, because infections (like bacterial conjunctivitis) can sometimes look similar to allergies, a doctor can check to ensure you don’t actually have an infection that needs antibiotics.
- In case of serious incidents: If glue gets into your eye (for example, a big drop falls in), immediately flush the eye with clean water for 5-10 minutes. Do not force your eye open if your lashes are stuck together – seek medical help or call a poison control center for guidance. Fortunately, such cases are extremely rare with trained professionals, but it’s worth mentioning. And of course, if you had trouble breathing or any sign of anaphylaxis, that’s an emergency – call for medical help.
- Aftercare for recovery: Avoid eye makeup and other potential irritants until your eyes are fully healed. Keep the area clean but don’t use harsh cleansers (a gentle baby shampoo diluted with water can clean your lids if needed). And give your eyes a break – it’s recommended to wait at least two weeks after an allergic reaction before attempting extensions again (you may even decide to discontinue extensions, or try alternatives like magnetic lashes if you’re very sensitive).
Remember, your eyes are precious. No beauty treatment is worth risking your vision or comfort. Most side effects of lash glue will resolve with proper care, but always err on the side of caution if something feels off.
✅ Safe & Sensitive-Skin Approved Lash Glues | WINLASH Dubai

When dealing with eyelash glue side effects, knowledge is power – and so is using the right product from the start. At Winlash Dubai, we take pride in offering safe, sensitive-skin approved lash adhesives that give you gorgeous lashes without the worry. Here are two top-rated options beloved by UAE lash professionals:
- DB Ultra Lash Glue – The sensitive speed-demon. This is a low-irritation, latex-free, formaldehyde-free adhesive that doesn’t compromise on performance. With an ultra-fast drying time, DB Ultra lets experienced lash artists work quickly. Despite its speed, it’s formulated to reduce fumes and sensitivity – clients report far less eye watering with DB Ultra compared to regular glues. It offers an exceptional hold (extensions can last for weeks with proper care). Plus, it’s oil-resistant and heat-resistant, crucial for withstanding Dubai’s climate. If you’re looking for the best eyelash glue for sensitive eyes that still delivers professional strength, DB Ultra is a top pick. (Internal link: Check out our DB Ultra Lash Glue in the store.)
- Sky Rose Eyelash Extension Glue – The humidity hero. This premium Korean-made adhesive is designed for professionals in high-humidity environments. It has a fast drying time and retention of several weeks, so lash sets last and last. Importantly for clients, Sky Rose has a low-fume formula that minimizes eye irritation even in Dubai’s humid air. It remains flexible and strong from 23°C up to 28°C and in 50–70% humidity– meaning no meltdown in the summer heat or when the humidity spikes. Sky Rose is latex-free and vetted by lash artists for reliable, irritation-free results. It’s perfect for volume lash experts who need a fast glue that won’t overwhelm clients’ eyes. (Fun fact: This glue is a go-to choice for many lash salons in Dubai because it consistently performs in our climate.)
Both of the above adhesives align with what we’ve discussed: they avoid harmful ingredients, they’re formulated to be safe eyelash extension glues for even sensitive clients, and they tackle the challenges of UAE weather by being low-fume lash glues. By choosing quality products like these, you significantly cut down the risk of side effects.
Ready to upgrade to a safer lash routine? Explore our full range of hypoallergenic, professional-grade lash glues in the Eyelash Extension Glue & Liquids category. Your eyes will thank you! (All Winlash adhesives are cruelty-free and tested to ensure they meet high safety standards.)
FAQs About Eyelash Glue Safety
Is eyelash extension glue safe for sensitive eyes?
Yes – if you choose the right type of glue. Look for hypoallergenic or sensitive formulas that are latex-free and formaldehyde-free. Many people with sensitive eyes do fine with professional low-fume adhesives, but react badly to cheap glues. Always do a patch test if you’re unsure, and avoid unknown or “bargain” products with potentially harsh ingredients.
Why does my eyelash glue burn my eyes during application?
That stinging or burning sensation usually comes from glue fumes reaching your eyes. When the adhesive is curing, it can release vapors that irritate the eye’s surface. Keeping your eyes fully closed and having the lash tech use low-fume glue plus proper ventilation (like a fan) will help. Also, glues dry slower in dry air, meaning fumes linger – so ensuring the humidity in the room is balanced can prevent that burning feeling.
Can I develop an allergy to lash glue even if I’ve been fine before?
Unfortunately, yes. Allergies to lash glue can develop over time after repeated exposure. You might get extensions for months with no issue, then suddenly experience red, swollen lids – that’s a sign you’ve become sensitized. If this happens, you’ll need to take a break from lash extensions and perhaps switch to a different glue formula (or only use hypoallergenic glues). Always inform your lash technician if you’ve had past reactions, even mild ones.
What’s the best eyelash glue for people with allergies?
For anyone prone to allergies, a medical-grade, sensitive eye adhesive is best. Look for products marketed as sensitive or hypoallergenic – for example, adhesives that are formaldehyde-free, latex-free, and low-fume. Some brands specifically make “sensitive” lash glue that might dry a bit slower but causes minimal irritation. Also, clear (no carbon-black) glue can be beneficial for those allergic to the black pigment. It may take some trial to find the perfect fit, but starting with high-quality, sensitive formulas (like the ones from Winlash’s collection) is the safest bet.
Final Thoughts
Beautiful lashes don’t have to come at the expense of your comfort or health. By understanding the potential side effects of eyelash glue – from minor irritation to serious allergies – you can take steps to prevent problems before they start. Always prioritize quality: choose safe, professional adhesives, insist on patch tests, and go to trained technicians who understand eye safety. Minor issues like a bit of redness can often be solved with simple tweaks (better ventilation, different glue), while major reactions are rare if you follow the guidelines we’ve covered.
In Dubai’s climate, pay extra attention to the products and techniques used, as heat and humidity can amplify issues. The good news is that with the right precautions, you can enjoy long, luscious extensions without red eyes or tears. If you’ve ever had a bad experience, don’t swear off lashes for good – instead, arm yourself with knowledge and maybe a new, gentler glue.
Finally, remember that your eyes are sending you signals. If they’re unhappy, don’t ignore them! It’s always okay to speak up or take a break from extensions if needed. Your safety and comfort are paramount.
Explore professional lash glues at Winlash — designed for safety, comfort, and durability even in Dubai’s humid climate. Happy lashing! 🎉

